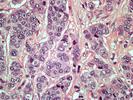

Nancy Shute appears in the following:
Will Your Child Become Nearsighted? One Simple Way To Find Out
Thursday, April 02, 2015
This is for everyone whose parents said, "Sitting too close to the TV is going to ruin your eyes." In other words, pretty much all of us.
Sitting too close to the TV doesn't predict nearsightedness, according to a study that tracked the vision of thousands of children over 20 ...
Diagnosing A Sinus Infection Can Be A DIY Project
Wednesday, April 01, 2015
Sinus infections are miserable, and it's hard not to want to run to the doctor for relief. Rethink that, the nation's ear, nose and throat doctors say.
Most people who get sinusitis feel better in a week, the doctors say, and many of those infections are caused by viruses. ...
Tweeners Trust Peers More Than Adults When Judging Risks
Tuesday, March 31, 2015
If you are the parent of a preteen, you are all too aware that they suddenly seem to value the opinions of their peers far more than yours.
The good news, if there is any, is that you're not alone. Young teenagers ages 12 to 14 are more influenced by ...
Patients Often Aren't Offered Minimally Invasive Surgery
Wednesday, March 25, 2015
It would be nice to think that when you go in for surgery you'd be offered the safest, cheapest alternative, but that's not always the case, a study finds.
Some hospitals are much more likely than others to offer minimally invasive surgery for procedures like colon or lung surgery or ...
If You're Going To Die Soon, Do You Really Need Statins?
Monday, March 23, 2015
It's easy to get put on statins, and it can be surprisingly hard to get off them. That's true even for people who are terminally ill and might have bigger concerns than reducing their cardiovascular risk.
People approaching the end of life who did stop statins were not more likely ...
For A Good Snooze, Take One Melatonin, Add Eye Mask And Earplugs
Thursday, March 19, 2015
Hospitals are one of the worst places to try to get a good night's sleep, just when you need it the most. And though many have tried to muffle the noise of beeping monitors and clattering carts, the noise remains a big problem for many patients.
But what if we ...
How Much Can Women Trust That Breast Cancer Biopsy?
Wednesday, March 18, 2015
When a woman is diagnosed with breast cancer, the person who does the diagnosing is a doctor she never sees — the pathologist.
But though pathologists do a great job of identifying invasive cancer, they aren't as good at spotting two less clear-cut diagnoses that bring women a lot of ...
Your Drinking Habits May Be Influenced By How Much You Make
Tuesday, March 17, 2015
To keep people from getting into trouble with alcohol, it would help to know why they're at risk.
Genes make some people more susceptible to dependence or addiction, while the surroundings exert a stronger pull on others. But it's been devilishly hard for researchers to sort those out. Context — ...
Genetic Disorder May Reveal How Statins Boost Diabetes Risk
Tuesday, March 10, 2015
Millions of people take statins to lower their cholesterol and reduce the risk of cardiovascular disease. But taking statins does slightly up the risk of Type 2 diabetes. Figuring out whether that means "No statins for you" isn't always easy, despite a proliferation of guidelines intended to help.
Here's in ...
Doctors Join Forces With Lawyers To Reduce Firearms Deaths
Thursday, February 26, 2015
Each year more than 32,000 people die in the United States as a result of suicides, homicides and accidents with firearms.
For years doctors have tried to reduce the toll by addressing gun injuries and deaths as a public health issue; there's ample evidence that ease of access to is ...
When Kids Think Parents Play Favorites, It Can Spell Trouble
Monday, February 23, 2015
Many Parents Aren't Sold On Later School Start Times For Teens
Tuesday, February 17, 2015
Sleeping in probably sounds like a no-brainer to most teenagers, but their parents aren't so sure that it's worth starting school later to get the extra shut-eye.
Half of parents with teenagers whose schools start before 8:30 am said they would like schools to start after that, according to a ...
What Microbes Lurk In The Subways Of New York? Mysteries Abound
Friday, February 06, 2015
If you were seeking a seething mass of microbes, it's hard to think of a better place to look than the New York City subway system.
Scientists who descended into that subterranean maze in search of its microbial tenants wanted to find out how the 1.7 billion people who use ...
Acupuncture May Help With Nasal Allergies, Doctors Say
Monday, February 02, 2015
If you've got a stuffy, drippy or itchy nose from allergies, figuring out which remedies help best can be tough.
New guidelines from the Academy of Otolaryngology should make it easier for people and their doctors to choose the treatments that will help the most, from over-the-counter remedies like antihistamines ...
Is It OK To Pay Pregnant Women To Stop Smoking?
Wednesday, January 28, 2015
Women who smoke while they're pregnant are more likely to have health problems, and their babies are at risk, too. But attempts to get women to stop smoking while pregnant usually fail.
When pregnant women in Scotland got paid to quit, 23 percent of them managed to stop smoking, compared ...
Imagining A Future When The Doctor's Office Is In Your Home
Monday, January 12, 2015
Extracting medical care from the health care system is all too often an expensive exercise in frustration. Dr. Eric Topol says your smartphone could make it cheaper, faster, better and safer.
That's the gist of his new book, The Patient Will See You Now. Lots of people are bullish on ...
Are Teenagers Capable Of Making Life-Or-Death Decisions?
Friday, January 09, 2015
The Connecticut Supreme Court's ruling that 17-year-old Cassandra could be forced to undergo cancer treatment sparked thousands of impassioned comments on NPR.org and Facebook.
Cassandra, who is being identified by her first name because she is a minor, had been removed from her home and put in the ...
How The Skin Disease Psoriasis Costs Us Billions
Thursday, January 08, 2015
Il Sogno Del Marinaio On World Cafe
Thursday, January 08, 2015
"I always will be a Minuteman. People ask what kind of bass player I am, and yeah, I tell 'em I'm D. Boon's bass player."
World Cafe's guest today, Mike Watt, is a great bass player who has played for a lot of people — and led the long-running band ...
Bariatric Surgery Cuts The Risk Of Death Years Later
Tuesday, January 06, 2015
Bariatric surgery is being widely promoted as the solution for people who are extremely obese, but so far most of the studies haven't followed enough people for enough time to really know if surgery helps improve health long term.
A study of patients who had the surgery through the Veterans ...